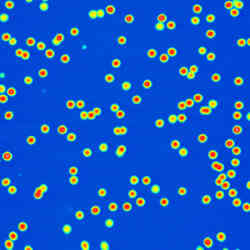
Polymer Nanoparticles

- Home
- Image Gallery
Select an application or technique:
Latest Images
High-Speed Imaging
AFM / OT and Advanced Optics
Life Sciences
Polymers
Nanoscience
Electrical, Magnetic and Thermal
Cell Mechanics and Adhesion
Single Molecule Force Spectroscopy
Nanomanipulation and Lithography
Raman, TERS and SNOM
Atomic Force MicroscopyAutomated Force SpectroscopyOptical TweezersCell/Tissue Mechanics and Adhesion
NanoWizard® NanoScience AFM
-
 MIPAM particle
MIPAM particle -
 JPK logo - piezo-response microscopy
JPK logo - piezo-response microscopy -
 DNA on octadecylamine
DNA on octadecylamine -
 Pentacene layers
Pentacene layers -
 Melting of a thin film of polystyrene
Melting of a thin film of polystyrene -
 Striped gold layer surface
Striped gold layer surface -
 QI™-CAFM on battery electrode
QI™-CAFM on battery electrode -
 QI™-EFM on NIPAM particles
QI™-EFM on NIPAM particles -
 QI™-KPM on an interdigitated electrode
QI™-KPM on an interdigitated electrode -
 Stretching of plastic Parafilm slide
Stretching of plastic Parafilm slide -
 Block-Co-Polymer thin section
Block-Co-Polymer thin section -
 Microrheology on silica beads
Microrheology on silica beads -
 Stretching of plastic film
Stretching of plastic film -
 Scanning thermal microscopy
Scanning thermal microscopy -
 PHB/V spherulite crystallization.
PHB/V spherulite crystallization. -
 PFM lithograthy
PFM lithograthy -
 CAFM on CU conduct layer
CAFM on CU conduct layer -
 MFM on NiFe square structure
MFM on NiFe square structure -
 KPM on SRAM
KPM on SRAM -
 Dendronized polymer
Dendronized polymer -
 Calcid - True atomic lattice resolution
Calcid - True atomic lattice resolution -
 Kraton
Kraton -
 Hexacontane
Hexacontane -
 Crystalline polyethylene at -120°C
Crystalline polyethylene at -120°C -
 Electrostatic Force Microscopy (EFM) on SRAM
Electrostatic Force Microscopy (EFM) on SRAM -
 Conductive QI™ measurement of a graphene flake
Conductive QI™ measurement of a graphene flake -
 Living KPG7 cell at 37°C - AFM and phase contrast
Living KPG7 cell at 37°C - AFM and phase contrast -
 Atomic resolution of mica taken on an optical microscope
Atomic resolution of mica taken on an optical microscope -
 Artificial polyprotein made of protein GB1
Artificial polyprotein made of protein GB1 -
 PTFE (Teflon™) layer
PTFE (Teflon™) layer -
 MFM on hard drive
MFM on hard drive -
 Kelvin Probe Microscopy (KPM) on an interdigitated electrode
Kelvin Probe Microscopy (KPM) on an interdigitated electrode -
 Optically active conductive polymer film
Optically active conductive polymer film -
 STM of arachidic acid molecules
STM of arachidic acid molecules -
 Electrical oxidation on silicon substrate
Electrical oxidation on silicon substrate -
 MFM images of rectangular magnetic structures
MFM images of rectangular magnetic structures -
 MFM images of a double T magnetic structure
MFM images of a double T magnetic structure -
 MFM images of six rectangular magnetic structures
MFM images of six rectangular magnetic structures -
 MFM images of a square magnetic structure
MFM images of a square magnetic structure -
 Breaking point analysis on nano fibres
Breaking point analysis on nano fibres -
 Hexacontane
Hexacontane -
 Dendronized polymer - QI™ mode
Dendronized polymer - QI™ mode -
 Polystyrene-block-polybutadiene film with QI™
Polystyrene-block-polybutadiene film with QI™ -
 Hexaphenyl nanofibers - AFM with fluorescence microscopy
Hexaphenyl nanofibers - AFM with fluorescence microscopy -
 Domain visualization in lithium niobate crystal (PFM)
Domain visualization in lithium niobate crystal (PFM) -
 Elastomeric polypropylene - 3D views
Elastomeric polypropylene - 3D views -
 Hexaphenyl nanofibers
Hexaphenyl nanofibers -
 Fluorescent polymer spheres - AFM with fluorescence microscopy
Fluorescent polymer spheres - AFM with fluorescence microscopy -
 Polyelectrolyte shell - AFM with DIC
Polyelectrolyte shell - AFM with DIC -
 Hollow microcapsules
Hollow microcapsules -
Polymer nanoparticles
Polymer nanoparticles -
 Polymer nanoparticle manipulation
Polymer nanoparticle manipulation -
 Polystyrene surface with holes
Polystyrene surface with holes -
 PHB-PHV spherulites
PHB-PHV spherulites -
 SBS triblock copolymer
SBS triblock copolymer -
 Langmuir blodgett film
Langmuir blodgett film -
 Patterned PDMS polymer
Patterned PDMS polymer -
 Lithography on polymer film
Lithography on polymer film -
 Thin polymer film
Thin polymer film -
 ITO on glass
ITO on glass

